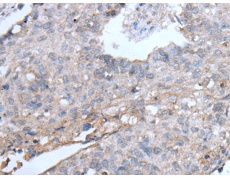
一抗

|
Background: |
This gene was identified based on the interaction of its protein product with thyroid hormone receptor beta. This protein is associated with the Golgi apparatus. The N-terminal region of the protein binds Golgi membranes and the C-terminal region binds the minus ends of microtubules; thus, the protein is thought to play a role in assembly and maintenance of the Golgi ribbon structure around the centrosome. Mutations in this gene cause achondrogenesis type IA. |
|
Applications: |
ELISA, IHC |
|
Name of antibody: |
TRIP11 |
|
Immunogen: |
Synthetic peptide of human TRIP11 |
|
Full name: |
thyroid hormone receptor interactor 11 |
|
Synonyms: |
ACG1A; CEV14; GMAP210; TRIP-11; TRIP230; GMAP-210 |
|
SwissProt: |
Q15643 |
|
ELISA Recommended dilution: |
5000-10000 |
|
IHC positive control: |
Human lung cancer |
|
IHC Recommend dilution: |
10-50 |

 購物車
購物車 幫助
幫助
 021-54845833/15800441009
021-54845833/15800441009